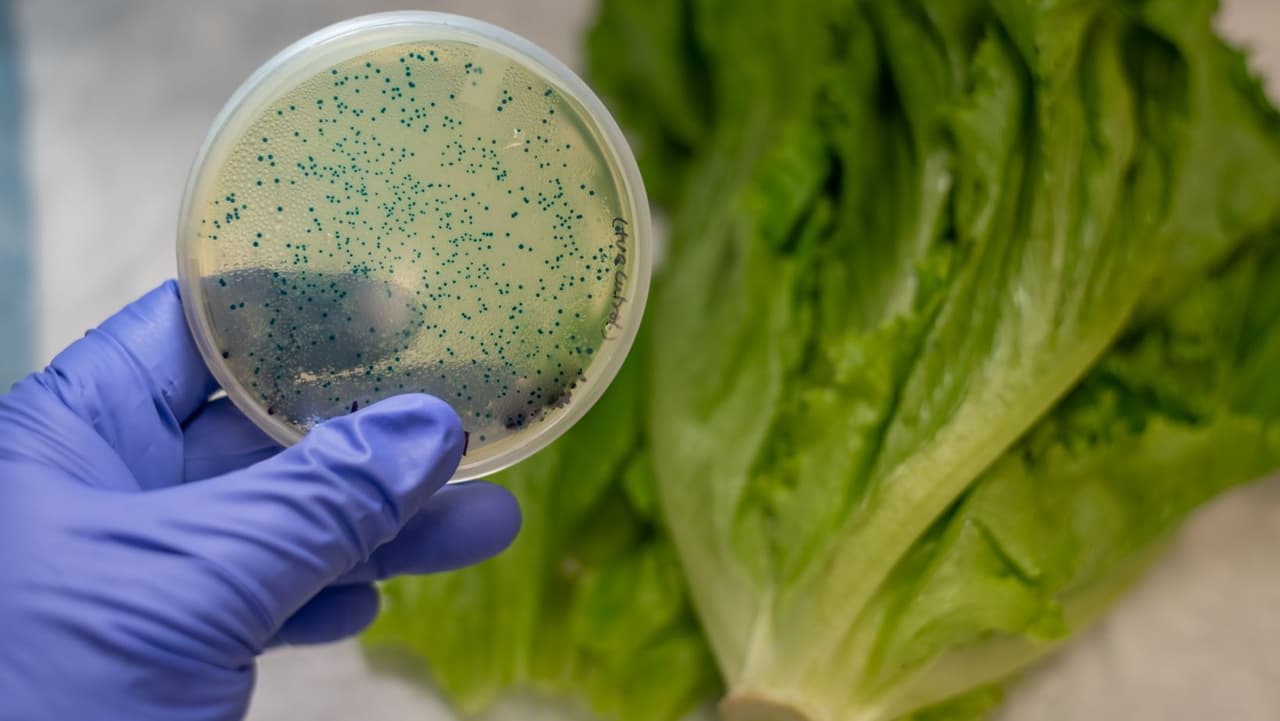
CDC informa brote de bacteria E. coli en Pensilvania y esto debes saber

Salud pública
Salud pública: Últimas noticias, videos y fotos de Salud pública
LO MÁS RECIENTE

Filadelfia entre las ciudades donde se analizará aguas residuales en la búsqueda de polio
El estudio se centra en ciudades y condados con baja cobertura de vacunación contra la poliomielitis y aquellos en los que los viajeros habían visitado las comunidades de Nueva York donde se encontró la poliomielitis.

Advierten sobre los peligros de Ozempic, el medicamento para la diabetes que muchos utilizan para adelgazar
Ozempic es un medicamento inyectable que se aplica por semana a las personas con diabetes. Sin embargo, se ha hecho muy popular como método para adelgazar. Y, ahora muchas personas, lo usan sin un control médico. El doctor Joseph Varón explica de qué se trata.

Experto médico alerta sobre Ozempic, el medicamento para la diabetes que muchos utilizan para adelgazar
“Ozempic es un medicamento que fue diseñado para los pacientes diabéticos que no requieren de insulina y llegó un momento en que se dieron cuenta que a la gente que le estaban dando estas inyecciones semanales bajaban mucho de peso”, contó el Dr. Joseph Varón, de United Memorial Medical Center en Houston, quien advirtió sobre su uso sin supervisión médica.
“Hay una epidemia”: aumenta la cantidad de niños contagiados con el virus sincitial respiratorio en Colorado
El doctor Edwin Asturias, especialista en enfermedades infecciosas, asegura que el virus sincitial respiratorio generalmente afecta a menores de un año; sin embargo, el experto explica que “como muchos pequeños en los últimos tres años no han tenido contacto con virus debido a las mascarillas hemos estado viendo infecciones en niños más grandes”. Lee aquí más noticias relacionadas con el virus sincitial respiratorio.

Aumentan los casos de envenenamiento infantil causados por medicamentos recetados para la tos
El medicamento, que viene en cápsulas de gel, se vende bajo la marca Tessalon. Se prescribe para tratar la tos causada por el resfriado común o la influenza, pero no está aprobado para niños menores de 10 años.

Recomiendan usar mascarillas en espacios cerrados en Los Ángeles tras aumento de casos de coronavirus
Tras el aumento de casos de coronavirus en el condado de Los Ángeles, los funcionarios de salud pública recomendaron usar nuevamente la mascarilla en espacios cerrados.